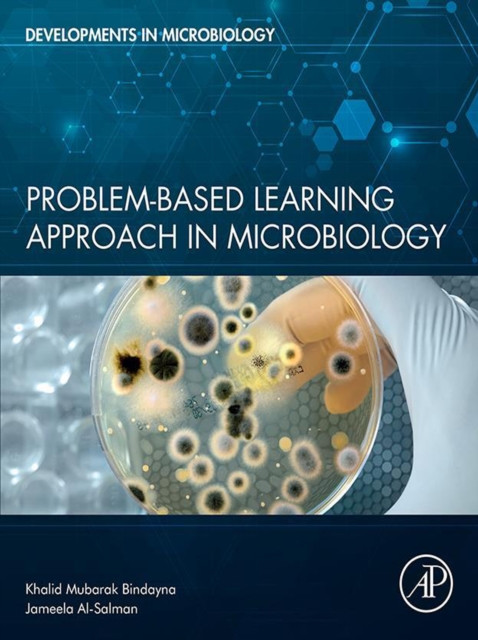
Problem-Based Learning Approach in Microbiology

More from publisher "Elsevier Science"
Shop allGenetic and Genomic Resources of Grain Legume ImprovementI. S. Bisht$85.00
Hydrogen Production, Transportation, Storage, and Utilization: Theoretical and Practical AspectsBahram Ghorbani$133.99
Massive MIMO in Practice: From 5G to 6GBilly Hogan$112.00
Problem-Based Learning Approach in MicrobiologyJameela Mohammed Al-Salman$146.00
Return to the River: Restoring Salmon Back to the Columbia RiverRichard N. Williams$62.99
Bio-Based Polymers and CompositesXiuzhi Susan Sun$83.00
Handbook of Neural Engineering: A Modern ApproachStephanie Willerth$155.00
International Encyclopedia of Human GeographyNigel Thrift$4,684.00
Corrosion and Corrosion Protection of Wind Power Structures in Marine Environments: Volume 2: Corrosion Protection MeasuresAndreas Momber$149.00
Managing Scientific Information and Research DataSvetla Baykoucheva$47.99
International Encyclopedia of EducationBarry McGaw$4,584.00
Drosophila: A Guide to Species Identification and UsePatrick O'Grady$75.00
 View productHydrogen Production, Transportation, Storage, and Utilization: Theoretical and Practical AspectsBahram Ghorbani$133.99
View productHydrogen Production, Transportation, Storage, and Utilization: Theoretical and Practical AspectsBahram Ghorbani$133.99 View productReturn to the River: Restoring Salmon Back to the Columbia RiverRichard N. Williams$62.99
View productReturn to the River: Restoring Salmon Back to the Columbia RiverRichard N. Williams$62.99 View productCorrosion and Corrosion Protection of Wind Power Structures in Marine Environments: Volume 2: Corrosion Protection MeasuresAndreas Momber$149.00
View productCorrosion and Corrosion Protection of Wind Power Structures in Marine Environments: Volume 2: Corrosion Protection MeasuresAndreas Momber$149.00